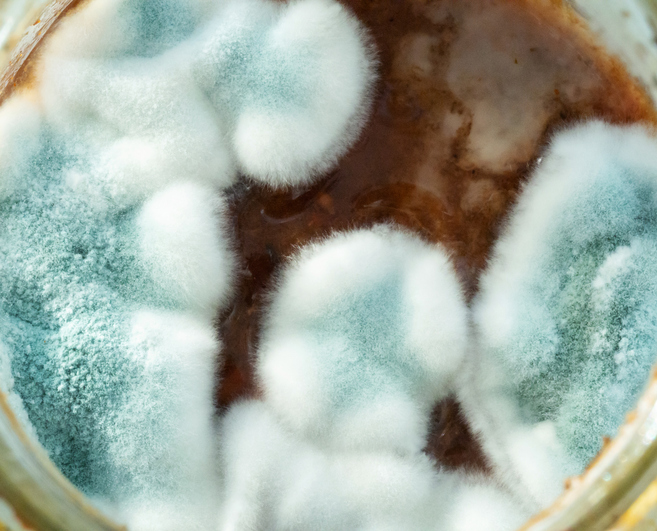

Note: Shortness of breath can be a symptom of coronavirus (COVID-19). Read more about coronavirus or use our Coronavirus Risk Assessment to check your risk.
Sudden shortness of breath, or breathing difficulty, is the most common reason for visiting a hospital accident and emergency department.
It's also one of the most common reasons people call for an ambulance.
It is normal to get out of breath when you have over-exerted yourself, but when breathlessness comes on suddenly and unexpectedly, it is usually a warning sign of a medical condition. The medical name for it is dyspnoea.
What you should do
You should call your doctor immediately if you have sudden shortness of breath, as there may be a problem with your airways or heart. Your doctor will assess you over the phone and may either visit you at home or admit you to hospital.
If your shortness of breath is due to anxiety, you may be asked to come to the surgery rather than a home visit.
Feeling that you cannot get enough air can be terrifying, but doctors are well trained in managing this. You will be given oxygen to breathe through a mask to help your symptoms while they investigate and treat the health condition causing your breathing problems.
If you have struggled with your breathing for a while, don't ignore it: see your doctor as it is likely that you have a long-term condition, such as obesity](yourmd:/condition/obesity), [asthma or chronic obstructive pulmonary disease, which will need managing properly.
The information below outlines the most common reasons for:
- shortness of breath that has come on suddenly
- shortness of breath that has lasted for a while
This guide should not be used to self-diagnose your condition, but should give you an idea of what is causing your breathlessness.
Causes of sudden shortness of breath
Sudden and unexpected breathlessness is most likely to be caused by one of the following health conditions. Click on the links below for more information about these conditions.
A problem with your lungs or airways
Sudden breathlessness could be an asthma attack. This means your airways have narrowed and you will produce more phlegm (sticky mucus), which will cause you to wheeze and cough. You will feel breathless because it will be difficult to move air in and out of your airways.
Your doctor may advise you to use a spacer device with your asthma inhaler. This will deliver more medicine to your lungs, helping to relieve your breathlessness.
Pneumonia (lung inflammation) may also cause shortness of breath and a cough. It is usually caused by an infection, so you will need to take antibiotics.
If you have chronic obstructive pulmonary disease (COPD), it is likely your breathlessness is a sign this condition has suddenly got worse.
A heart problem
It is possible to have a "silent" heart attack without experiencing all the obvious symptoms, such as chest pain and overwhelming anxiety. In this case, shortness of breath may be the only warning sign you are having a heart attack. If you or your doctor think this is the case, they will give you aspirin and admit you to hospital straight away.
Heart failure can also cause breathing difficulties. This life-threatening condition means your heart is having trouble pumping enough blood around your body, usually because the heart muscle has become too weak or stiff to work properly. It leads to a build-up of water inside the lungs, which makes breathing more difficult.
A combination of lifestyle changes and medicines or surgery will help the heart pump better and relieve your breathlessness.
Breathlessness could also relate to a problem with your heart rate or rhythm, such as atrial fibrillation (an irregular and fast heart rate) or supraventricular tachycardia (regular and fast heart rate).
Panic attack or anxiety
A panic attack](yourmd:/condition/panic-disorder) or [anxiety can cause you to take rapid or deep breaths, known as hyperventilating. Concentrating on slow breathing or breathing through a paper bag should bring your breathing back to normal.
More unusual causes
These include:
- partial collapse of your lung caused by a small tear in the lung surface, which allows air to become trapped in the space around your lungs (this is known as pneumothorax)
- a blockage in one of the blood vessels in the lung (known as a pulmonary embolism)
- a collection of fluid next to the lung (called pleural effusion)
- a complication of diabetes known as diabetic ketoacidosis, where acids build up in your blood and urine
Causes of breathlessness that has lasted a while
Long-term breathlessness is usually caused by:
- obesity or being unfit
- asthma that is not controlled properly
- chronic obstructive pulmonary disease (COPD), which is permanent damage to the lungs usually caused by years of smoking
- anaemia, which is a low level of oxygen in the blood due to a lack of red blood cells or lack of haemoglobin (the part of red blood cells that carries oxygen)
- heart failure, which means your heart is having trouble pumping enough blood around your body, usually because the heart muscle has become too weak or stiff to work properly
- a problem with your heart rate or rhythm, such as atrial fibrillation (an irregular and fast heart rate) or supraventricular tachycardia (regular and fast heart rate).
Click on the links above for more information on these conditions.
More unusual causes of long-term breathlessness are:
- a lung condition called bronchiectasis, where the airways are abnormally widened and you have a persistent phlegmy cough
- a recurrent blockage in one of the blood vessels in the lung (known as a pulmonary embolism)
- partial collapse of your lung caused by lung cancer
- a collection of fluid next to the lung (pleural effusion)
- narrowing of the main heart valve, restricting blood flow to the rest of the body
- frequent panic attacks, which can cause you to hyperventilate (take rapid or deep breaths)